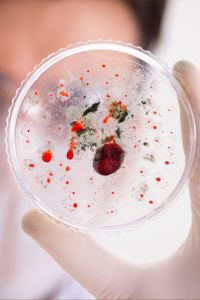

Schäden & Mängel am Bau
Eine unserer Kernkompetenzen ist das Bauschadensmanagement. Dies beinhaltet u.a. die Begutachtung und Bewertung von Bauschäden und Baumängeln sowie das Erstellen von kosteneffizienten und weitsichtigen bautechnischen Analysen und Sanierungskonzepten.
Eine auf den Kunden und sein Bauobjekt zugeschnittene individuelle Beratung erfolgt auf der Grundlage von Ortsbesichtigungen und schriftlichen Unterlagen. Je nach Wunsch und Erfordernis erstellen wir Dokumentationmen über die bauliche Qualität in Form von Kurzstellungnahmen bis hin zu umfangreichen Gutachten und Fotodokumentationen. Bei Bedarf kalkulieren wir die Schadenshöhe, ggf. den Minderwert oder erstellen ein Sanierungskonzept.
Unsere Gutachten sind für den Verbraucher zweckmäßig, verständlich formuliert und vollständig nachvollziehbar. Sie enthalten eine fachlich begründete Beurteilung der baulichen Leistung und Schadensursache. Durch unsere öffentliche Bestellung und Vereidigung sowie Zertifizierung besitzen wir eine besondere Vertrauenswürdigkeit vor Gericht.
Es ist unser erstes Anliegen, mit Hilfe des Gutachtens einen Rechtsstreit zu vermeiden. Sollte dennoch ein Rechtsstreit unabwendbar sein, begleiten wir sie mit technischen Expertisen durch das gesamte Verfahren.
Wir sorgen für eine nachhaltige Steigerung der Bauqualität.
Leistungen im Überblick
während aller baulichen Maßnahmen für ein neu zu errichtendes Objekt sowie bei der Sanierung oder dem Umbau eines Bestandsgebäudes.
Eine standardisierte Baukontrolle bietet Vorteile. Sie wird aber in der Regel den persönlichen Kundenwünschen und einem individuellen Gebäude nicht gerecht.
Aus diesem Grund erfolgen unsere individuellen Qualitätskontrollen in gemeinsamer Absprache entsprechend den Kundenbedürfnissen und den Anforderungen des Objektes. Auf diese Weise erfährt der Bauherr eine persönliche Baubetreuung vor, während und nach allen baulichen Maßnahmen.
Eine kontinuierliche Bauberatung kann auf Wunsch hin in Form sorgfältiger stichprobenhafter Ortsbesichtigungen bis hin zu einer intensiven Baubegleitung der vier wichtigsten Bauphasen (Bodenplatte, Rohbau, technische Grundausrüstung, Ausbau) erfolgen. Bei den Terminen orientieren wir uns regelmäßig an den kritischen Bauphasen, den s.g. "Schnittstellen".
Auf Wunsch unterstützen wir den Bauherrn als dessen technische Berater bei der Vertragsunterzeichnung, der technischen Prüfung des Bauvertrages, der Auswahl von geeigneten Baumaterialien oder der Beschreibung des gewünschten Qualitätsstandarts.
Am Ende der Bauphase begleiten wir den Bauherrn bei der technischen Abnahme des Objektes.
Wir unterstützen Bauherrn bei der technischen Abnahme von Ein- und Mehrfamilienhäusern, Sonder- und Gemeinschaftseigentum oder Gewerbeimmobilien und der anschließenden Objektübergabe.
Durch die Bauabnahme erhält der Bauherr die Gelegenheit zu überprüfen, ob die vereinbarten und die erbrachten Leistungen mit dem Bau-Soll übereinstimmen.
Wir unterstützen den Auftraggeber an diesem wichtigen Tag. Durch uns als unabhängige Sachverständige werden in einem Abnahmeprotokoll eventuelle Restarbeiten, Beanstandungen und Mängel für Auftraggeber und Auftragnehmer transparent erfasst.
Mit der Abnahme beginnt die Gewährleistungsfrist. Der Bauherr als Auftraggeber darf die Abnahme nicht grundlos verweigern.
Grundsätzlich empfehlen wir eine Vorbegehung um einen reibungslosen Ablauf der förmlichen Abnahme zu gewährleisten.
Die Abnahme einer neu gebauten Eigentumswohnung gestaltet sich durch die Unterteilung in Sonder- und Gemeinschaftseigentum für den Laien meist kompliziert.
Gerne untersützen wir sie.
Nach Ablauf der Gewährleistungsfrist verfällt jeglicher Anspruch auf die Beseitigung baulicher Mängel (ausgenommen der „Mängel aus Arglist“). Aus diesem Grund ist das Erkennen und die Dokumentation aller Mängel vor Ablauf der Gewährleistung unerlässlich.
Die Gewährleistungsfrist beträgt in der Regel zwei, vier bzw. fünf Jahre nach Abnahme der Bauleistung.
Bei der Gewährleistungsbegehung und einer eventuell erforderlichen Mängelanzeige nach Abnahme unterstützen wir sie gerne.
Mängelansprüche sind bei einem Kauf einer Bestandsimmobilie weitgehend ausgeschlossen.
Durch uns als unabhängige Sachverständige erhält der Kunde vor dem Kauf einer Immobilie Sicherheit für sein wirtschaftliches Handeln. Als erfahrene und neutrale Experten beurteilen wir Risiken, Folgekosten und den rechtlichen Rahmen. Wir erhöhen ihre Entscheidungskompetenz bei gleichzeitiger Minimierung der Risiken.
Die wirtschaftliche Risikoberatung auf Grundlage einer ausführlichen Objektbesichtigung und Vor-Ort-Beratung umfasst die Beurteilung der Bausubstanz, evtl. Schadstoffe, Instandhaltungsstau oder Mängel sowie erforderlicher Sanierungs- und Instandhaltungskosten.
Ein auf Wunsch erstelltes Modernisierungs- , Renovierungs- oder Sanierungskonzept ermöglicht eine bessere wirtschaftliche Planung.
Schriftlicher Mängelbericht
Ein schriftlicher Mängelbericht vor oder ein Mängelgutachten nach dem Kauf der Immobilie nennt bestehende Mängel, Bauschäden oder den Instandhaltungsstau. In Absprache kann dies in Form eines Kurzberichtes bis zu einem umfangreichen gerichtlichen Privatgutachten erfolgen.
Grundlage einer jeden Sanierung und Modernisierung ist ein erfolgreiches Schadensmanagement.
Wir ermöglichen ihnen die bessere Planung der erforderlichen Instandhaltungsmaßnahmen auf dem Hintergrund der Wirtschaftlichkeit und des gesunden Bauens.
Dies geschieht je nach Kundenwunsch im Rahmen eines einfachen Modernisierungschecks und mündlicher Beratung bei einer vor Ort Besichtigung bis hin zur Erstellung einer Objektzustandsdokumentation oder umfangreicher Sanierungskonzepte.
Auf der Basis jahrzehntelanger Erfahrung bei der Bauplanung und Bauausführung sowie in der Baustoffindustrie ermitteln wir als Experten geeignete Baustoffe unter Berücksichtigung ihrer Vor- und Nachteile. Zwecks Rentabilität und Optimierung erfolgt der Vergleich von verschiedenen Anbietern.
Könnte eine bauliche Maßnahme Schäden an einer Nachbarbebauung verursachen, ist zur sicheren Abgrenzung zwischen Alt- und Neuschäden die Feststellung des baulichen Zustandes vor der entsprechenden baulichen Maßnahme unabdingbar.
Eine Objektzustandsdokumentation minimiert die Risiken und verschafft Sicherheit im Falle einer gefärdeten Bausubstanz durch z.B. Unterfangungen, Grundwasserabsenkungen, Abbrucharbeiten oder Erschütterungen.
Nach einer Prüfung der Unterlagen und einer Besichtigung vor Ort erstellen wir ein ein Besichtigungsprotokoll in dem Objektzustand und Objektumfeld dokumentiert werden. Qualifizierte Fachkräfte und erprobte Messtechniken wie der Einsatz von Rissmonitoren oder Erschütterungsmessungen ermöglichen umfangreiche Analysen.
Eine Ausführliche Dokumentation dient der Beweissicherung.
Als ausgebildete Mediatoren unterstützen wir die Konfliktlösung bei bautechnischen Streitfragen.
Als gelernte Handwerker, ehemalige Bauherrnvertreter, Bauplaner und durch jahrelange Erfahrung sind uns die Wünsche und Bedürfnisse aller am Bau Beteiligten berstens bekannt. Aus unserer Tätigkeit als Gerichtssachverständige wissen wir, dass diese Wünsche in einem Rechtsstreit selten vollständig in Erfüllung gehen.
Unser Bemühen ist es, durch Mediation als ein außergerichtliches Verfahren zur Lösung von Konflikten, eine für alle Seiten vorteilhafte Lösung zu finden. Als neutraler Dritter führen wir durch den Konflikt. Anders als ein Richter entscheiden wir nicht, sondern helfen den Parteien einen gemeinsamen Konsens und eine interessengerechte Lösung zu finden. Hierbei arbeiten wir eng mit Richtern und Fachanwälten für das Bau- und Architektenrecht zusammen.
Am Ende der Mediation kann eine rechtsverbindliche Vereinbarung stehen. So kann eine jahrelange juristische Auseinandersetzung vermieden werden und ein partnerschaftliches Miteinander bleibt in der Zukunft möglich.
Baustoffprüfungen, Prüfungen auf Schadstoff- und Schimmelpilzbefall, Feuchtebelastung & Schädlinge

Moderne zerstörungsfreie oder zerstörende Untersuchungen:
Bei Bedarf koordinieren wir eine Bauteilöffnung- und Verschließung durch einen Fachbetrieb.
Baustoffbeprobung: Zusammenarbeit mit zerifizierten Laboren

Umfangreiche Anlayse durch qualifizierte Fachkräfte und erprobte Messtechniken:
insbesondere Feuchtemessungen, Schimmelpilzbeprobung, Beprobung auf Schadstoffe

Beratung Gesundes Wohnen:
Auf der Grundlage der gesetzlichen Regelungen und nach dem Stand von Wissenschaft und Technik
